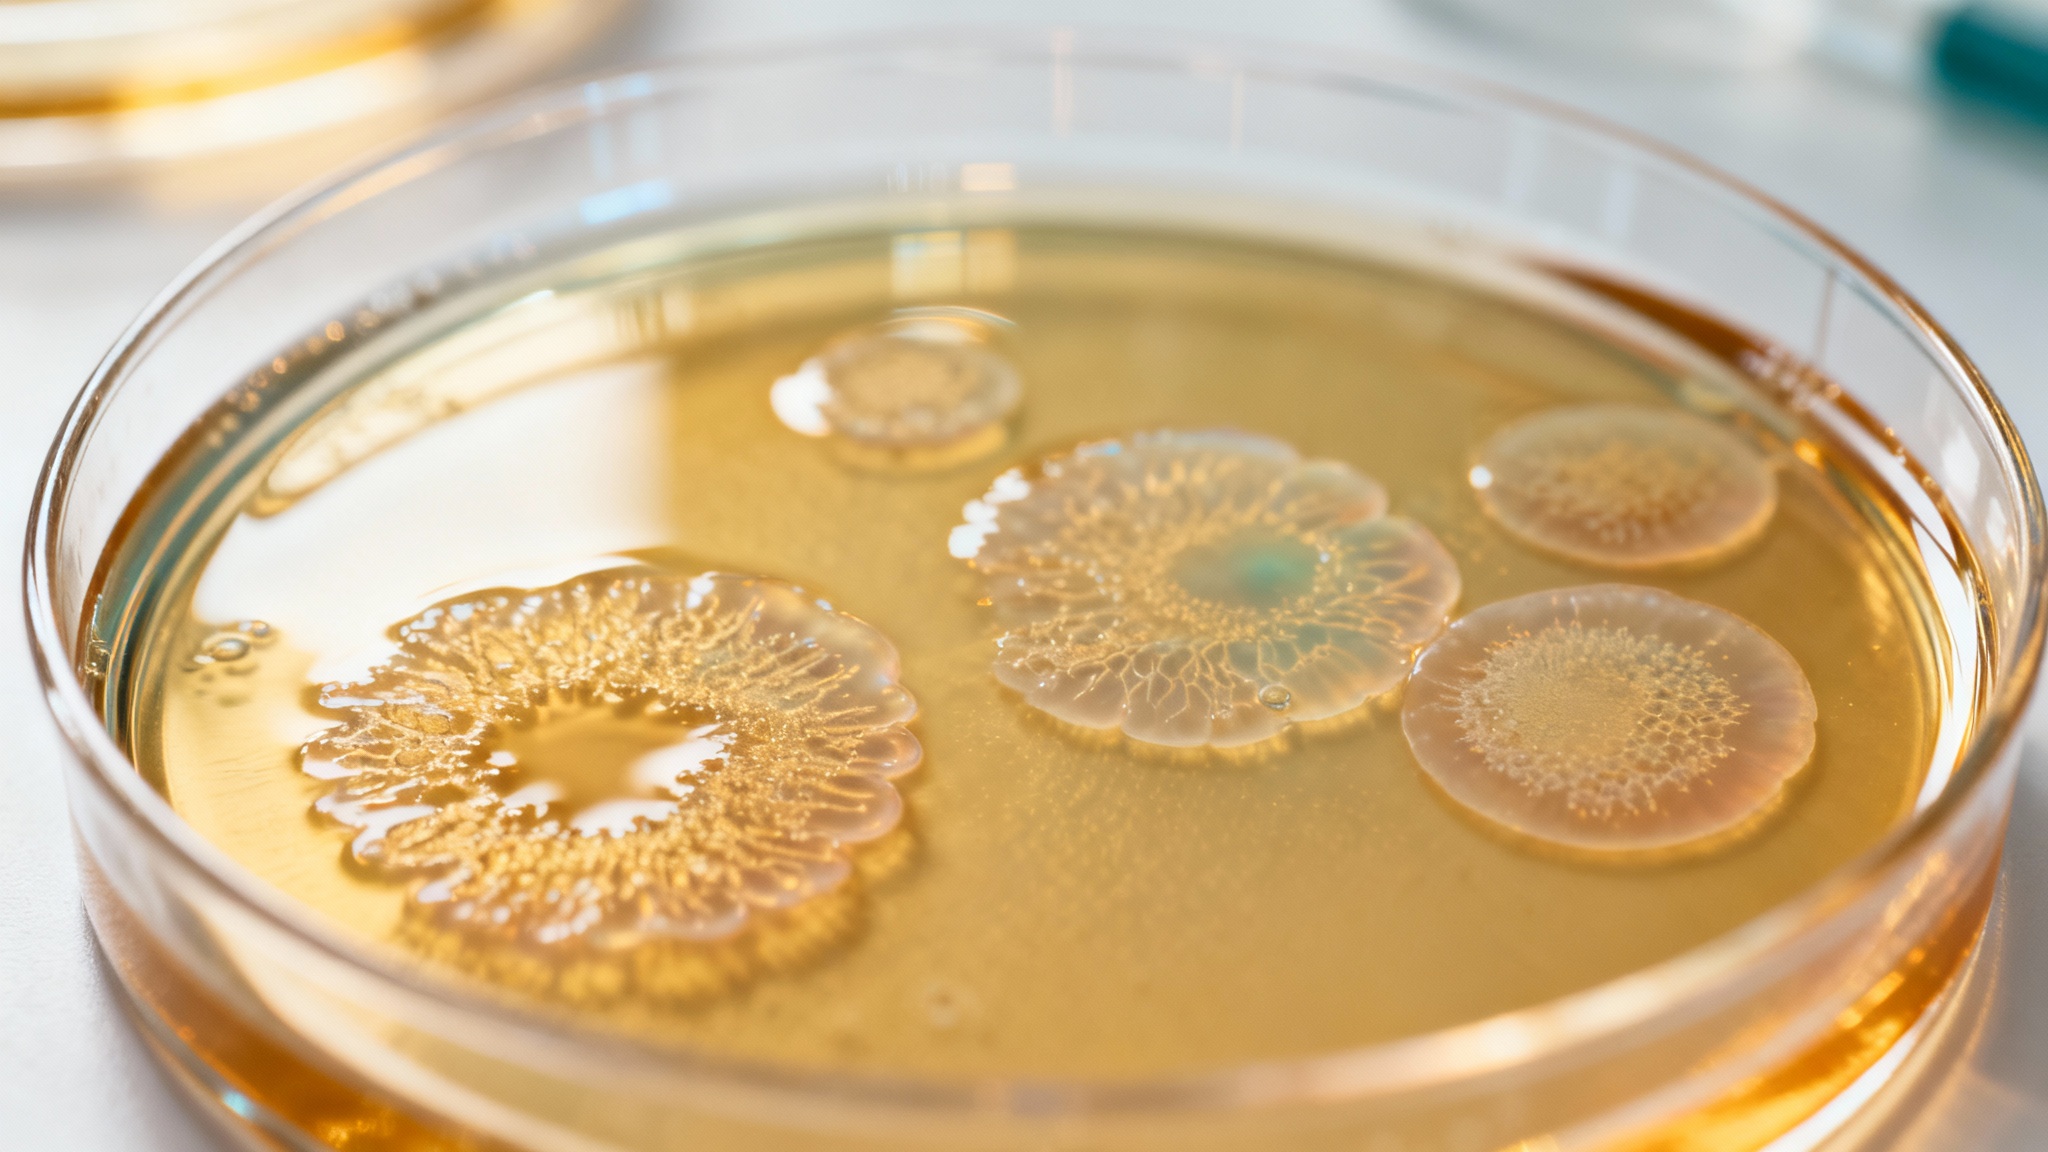

Des bactéries intestinales qui produisent de la sérotonine : une révolution pour traiter le syndrome de l’intestin irritable ?
Auteur: Mathieu Gagnon
Une nouvelle surprenante pour notre ventre

On parle souvent de maux de ventre, de ballonnements… Pour beaucoup, c’est le quotidien du syndrome de l’intestin irritable (SII). Un mal bien réel, qui touche d’ailleurs plus de femmes que d’hommes. Mais une découverte récente pourrait bien changer la donne. Des chercheurs en Suède ont mis le doigt sur un lien vraiment étonnant entre ce que nous avons dans nos intestins et notre bien-être général. Et si la solution venait de minuscules habitants de notre corps ?
La sérotonine, bien plus qu’une histoire de cerveau

Quand on entend le mot ‘sérotonine’, on pense presque toujours au cerveau, à notre humeur. C’est vrai, mais ce n’est qu’une toute petite partie de la vérité. Imaginez un peu : plus de 90 % de toute la sérotonine de notre corps est en fait fabriquée dans notre tube digestif ! C’est elle qui donne les ordres à nos intestins pour qu’ils se contractent comme il faut et fassent leur travail correctement. C’est un peu le chef d’orchestre de notre digestion, ce qu’on appelle parfois notre ‘deuxième cerveau’.
Des bactéries qui fabriquent le ‘bonheur’ intestinal
Jusqu’à maintenant, les scientifiques pensaient que nos bactéries intestinales pouvaient, au mieux, influencer notre production de sérotonine, mais pas la fabriquer elles-mêmes. Eh bien, il faut croire qu’on se trompait. Cette nouvelle étude a identifié deux bactéries bien spécifiques : Limosilactobacillus mucosae et Ligilactobacillus ruminis.
Quand les chercheurs les ont introduites chez des souris de laboratoire qui manquaient de sérotonine, les niveaux sont remontés en flèche. Mieux encore, le temps de transit intestinal, souvent un problème dans le SII, est redevenu normal. C’est quand même incroyable, non ? Qui aurait pu penser que ces petites bêtes avaient un tel pouvoir ?
Le lien direct avec le syndrome de l’intestin irritable

Alors, quel est le rapport avec le SII ? C’est là que ça devient vraiment passionnant. Les scientifiques ont regardé de plus près et ont remarqué que les personnes qui souffrent de ce syndrome avaient des niveaux plus faibles d’une de ces fameuses bactéries (la L. mucosae) dans leurs selles, par rapport aux personnes en parfaite santé digestive.
Cela suggère très fortement qu’un manque de ces ‘bonnes’ bactéries pourrait être l’une des clés pour comprendre les symptômes si désagréables comme la douleur, la constipation ou la diarrhée. C’est une piste très sérieuse.
Ce qu’en disent les chercheurs
Les professeurs Fredrik Bäckhed et Magnus Simrén, qui ont dirigé cette étude, ne cachent pas leur enthousiasme. Fredrik Bäckhed trouve ‘incroyablement fascinant’ que des bactéries puissent produire des molécules aussi importantes pour notre santé. De son côté, Magnus Simrén explique que ces résultats ‘ouvrent de nouvelles voies pour le traitement’ des troubles digestifs comme le SII.
Ils pensent même que c’est peut-être la clé pour enfin comprendre comment notre intestin et ses habitants peuvent influencer notre cerveau et même notre comportement. C’est toute une nouvelle porte qui s’ouvre sur la médecine de demain.
Conclusion : Un véritable espoir pour l’avenir

Pour résumer, cette découverte n’est pas juste une ligne de plus dans un journal scientifique. C’est un véritable espoir pour des millions de personnes. L’idée que l’on pourrait, un jour, traiter le syndrome de l’intestin irritable en agissant directement sur certaines bactéries de notre flore intestinale, c’est une perspective formidable. Bien sûr, il reste encore du chemin à parcourir, mais savoir que la solution à nos maux de ventre se trouve peut-être déjà en nous, c’est une pensée vraiment réconfortante.
Ce contenu a été créé avec l’aide de l’IA.










